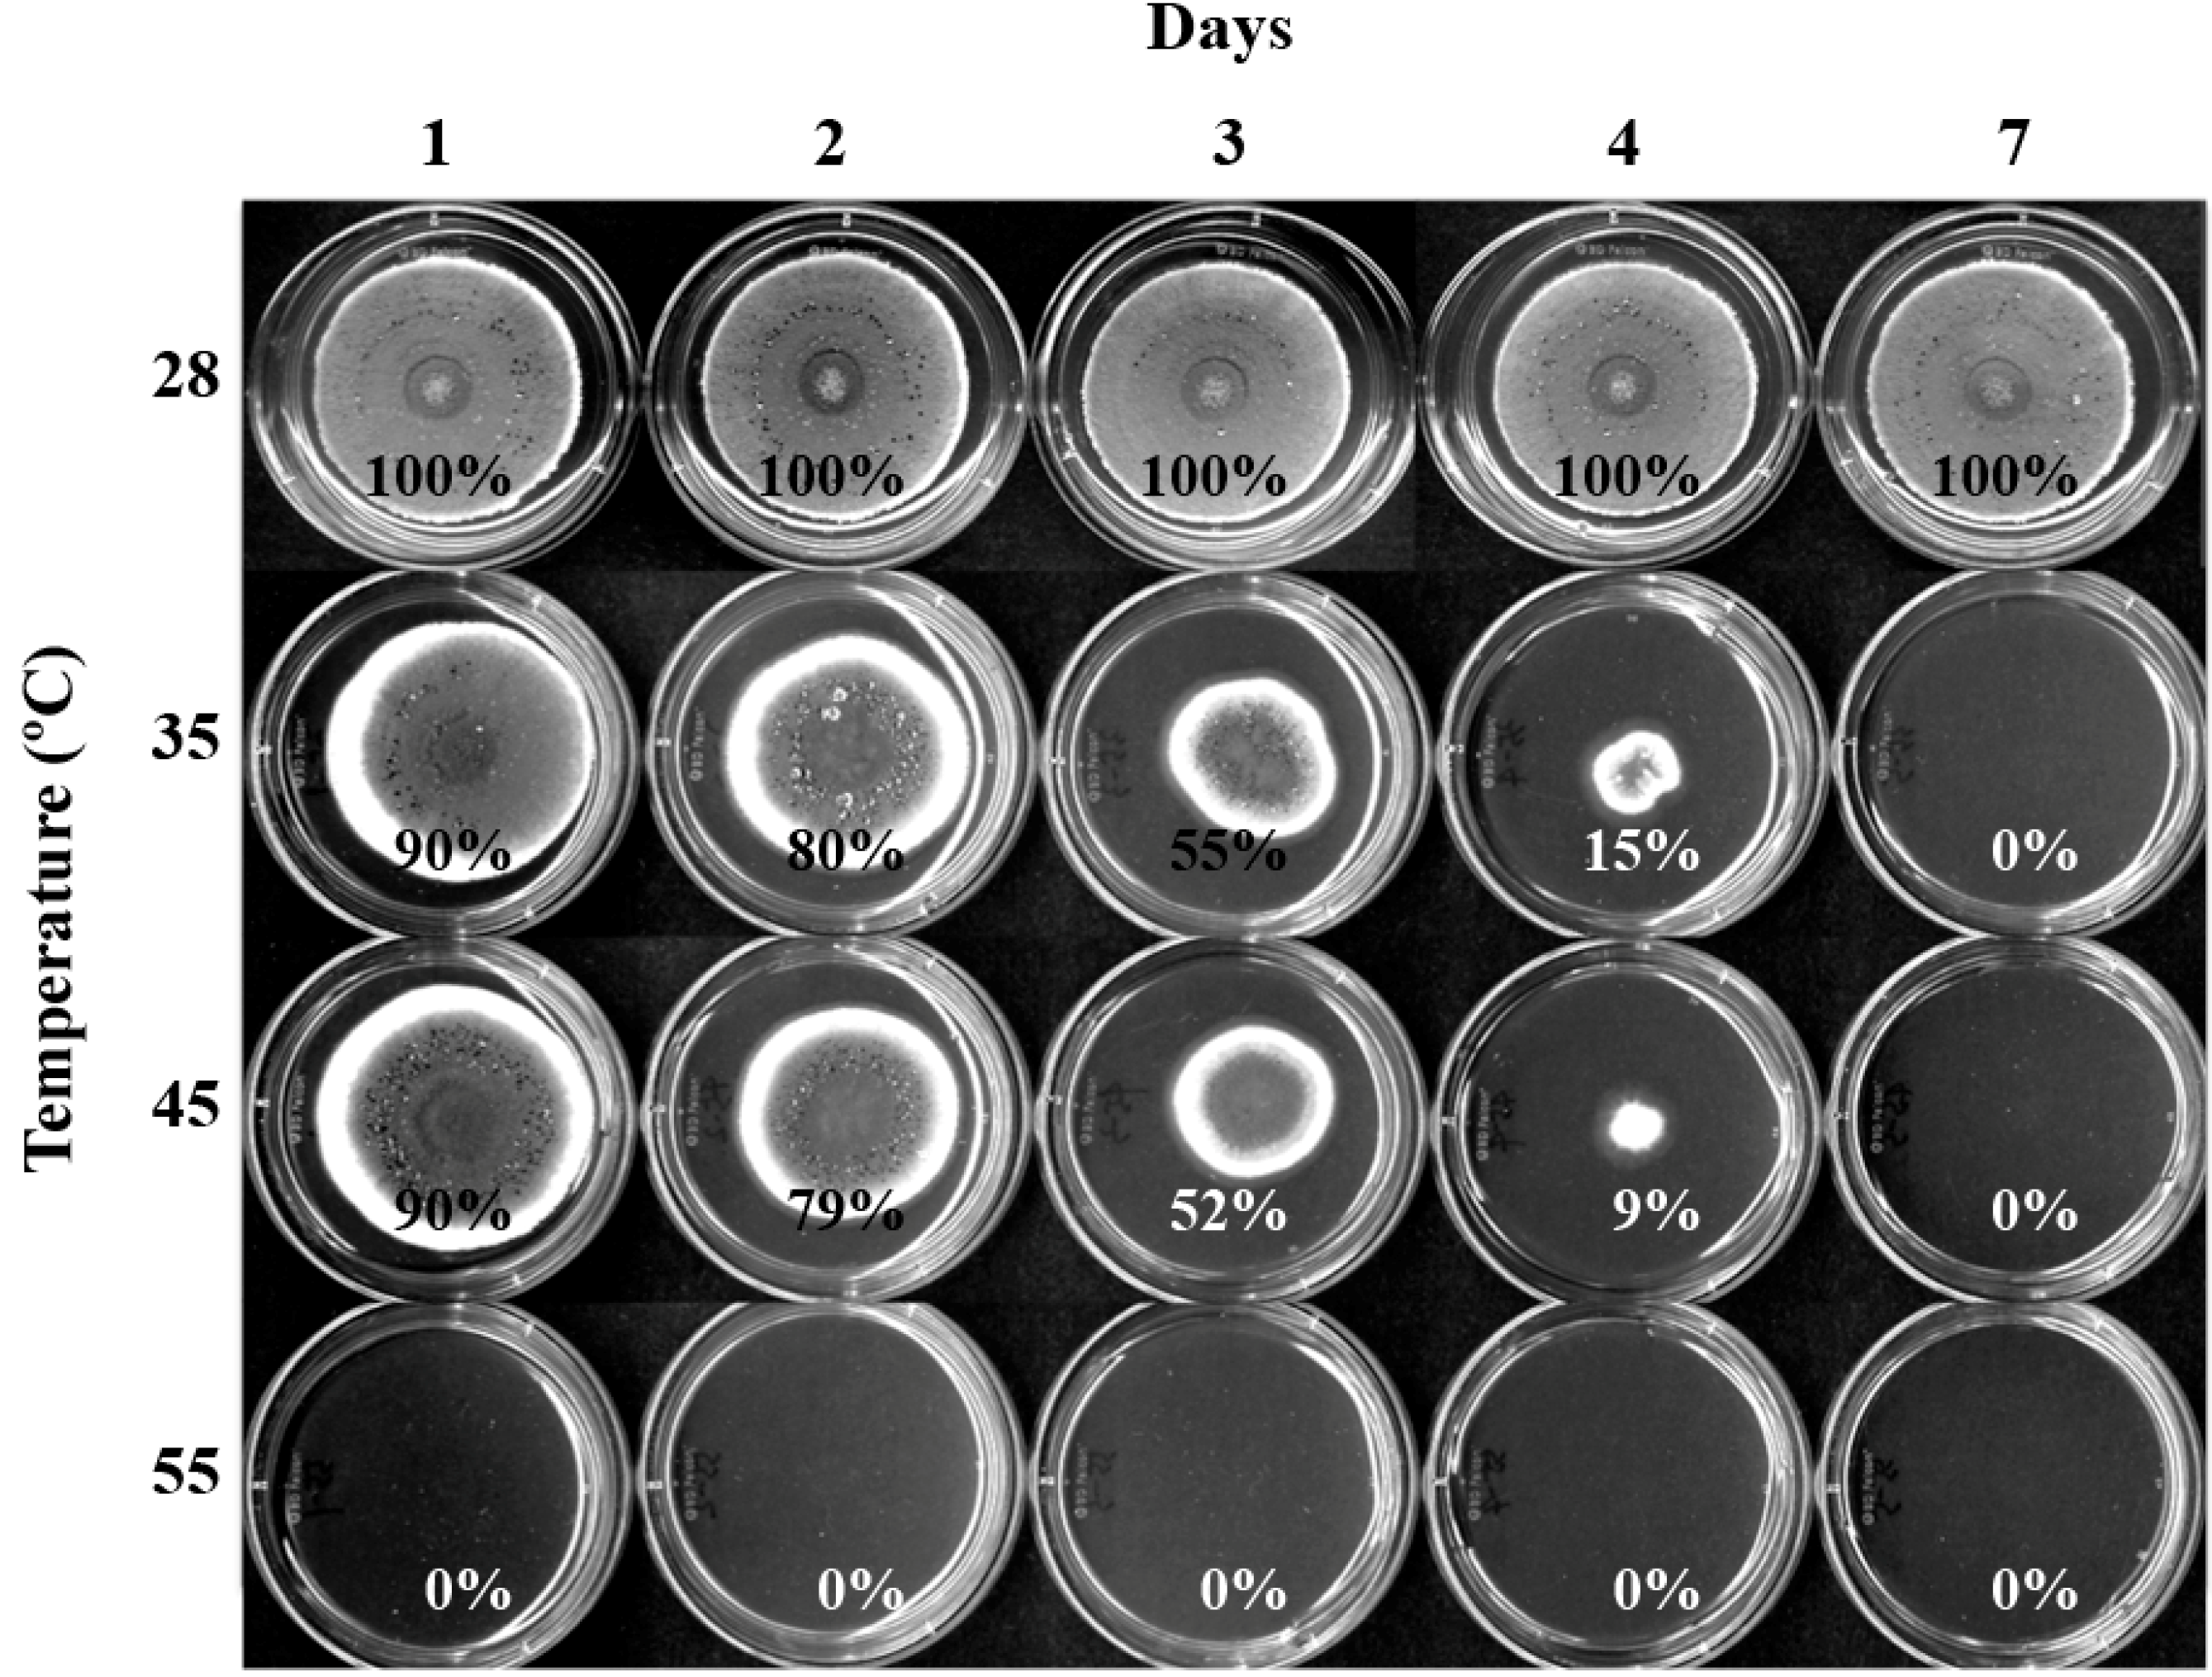
Molecules 19 18448 g002

Augmenting the Antifungal Activity of an Oxidizing Agent with Kojic Acid: Control of Penicillium Strains Infecting Crops
Abstract
:1. Introduction

| Penicillium Strains | Strain Characteristics | Source/Reference |
|---|---|---|
| Group A (P. expansum): | ||
| P. expansum W1 | Plant pathogen (Parental strain) | [26] |
| P. expansum FR2 | Plant pathogen, Fludioxonil resistant mutant derived from P. expansum W1 | [26] |
| P. expansum W2 | Plant pathogen (Parental strain) | [26] |
| P. expansum FR3 | Plant pathogen, Fludioxonil resistant mutant derived from P. expansum W2 | [26] |
| Group B (Other Penicillium strains): | ||
| P. glabrum 766 | Plant pathogen | NRRL a |
| P. chrysogenum 824 | Fleming’s penicillin-producing strain | NRRL |
| P. griseofulvum 2159 | Plant pathogen | NRRL |
| Group C (Citrus pathogens): | ||
| P. digitatum 786 | Plant pathogen | NRRL |
| P. italicum 983 | Plant pathogen | NRRL |
2. Results and Discussion
2.1. Susceptibility of P. expansum W1 to High Temperatures
2.2. Susceptibility of Penicillium Strains to Chemosensitization
2.2.1. Effect of Co-Application of KA with H2O2 on Fungal Growth: at 24 h
2.2.2. Effect of Co-Application of KA with H2O2 on Fungal Growth: at 48 h
| Group A (P. expansum W1, FR2, W2, FR3) | |||||||
|---|---|---|---|---|---|---|---|
| 28 °C | |||||||
| Compounds | MIC Alone | MIC Combined | FICI | MFC Alone | MFC Combined | FFCI | |
| Mean | KA | 25.6 | 7.2 | 0.7 | 25.6 b | 10.4 | 0.9 |
| H2O2 | 4.0 | 1.8 | 4.0 | 2.0 | |||
| t-test | KA | - | p <0.005 | - | - | p <0.005 c | - |
| H2O2 | - | p <0.005 | - | - | p <0.005 | - | |
| 35 °C | |||||||
| Mean | KA | / | / | / | 25.6 | 12.8 | 0.8 |
| H2O2 | / | / | 1.5 | 0.5 | |||
| t-test | KA | - | / | - | - | p <0.005 | - |
| H2O2 | - | / | - | - | p <0.05 | - | |
| 45 °C | |||||||
| Mean | KA | / | / | / | 25.6 | 16.0 | 0.6 |
| H2O2 | / | / | 0.4 | 0.2 | |||
| t-test | KA | - | / | - | - | p <0.05 | - |
| H2O2 | - | / | - | - | P, insignificant | - | |
| Group B (P. glabrum 766, P. chrysogenum 824, P. griseofulvum 2159) | |||||||
| 28 °C | |||||||
| Mean | KA | 25.6 | 17.6 | 1.4 | 25.6 | 13.9 | 1.1 |
| H2O2 | 8.0 | 5.3 | 8.0 | 4.7 | |||
| t-test | KA | - | P, insignificant | - | - | P, insignificant | - |
| H2O2 | - | P, insignificant | - | - | P, insignificant | - | |
| 35 °C | |||||||
| Mean | KA | 25.6 | 11.7 | 1.0 | 25.6 | 19.2 | 1.4 |
| H2O2 | 2.3 | 1.3 | 4.0 | 2.7 | |||
| t-test | KA | - | P, insignificant P, insignificant | - | - | P, insignificant | - |
| H2O2 | - | P, insignificant | - | ||||
| 45 °C | |||||||
| Mean | KA | / | / | / | / | / | /, ND d |
| H2O2 | / | / | / | / | |||
| t-test | KA | - | / | - | - | / | - |
| H2O2 | - | / | - | - | / | - | |
| Group C (P. italicum 983, P. digitatum 786) | |||||||
| 28 °C | |||||||
| Mean | KA | 25.6 | 12.8 | 1.0 | 25.6 | 25.6 | 2.0 |
| H2O2 | 3.0 | 1.5 | 3.0 | 3.0 | |||
| t-test | KA | - | ND e | - | - | ND e | - |
| H2O2 | - | ND e | - | - | ND e | - | |
| 35 °C | |||||||
| Mean | KA | / | / | / | 25.6 | 19.2 | 1.4 |
| H2O2 | / | / | 0.6 | 0.4 | |||
| t-test | KA | - | / | - | - | ND e | - |
| H2O2 | / | - | ND e | - | |||
| 45 °C | |||||||
| Mean | KA | / | / | / | / | / | /, ND f |
| H2O2 | / | / | / | / | |||
| t-test | KA | - | / | - | - | / | - |
| H2O2 | / | - | / | - | |||

2.2.3. Effect of High Temperatures on the Growth of Fludioxonil-Resistant Mutants

3. Experimental Section
3.1. Fungal Strains and Culture Conditions
3.2. Chemicals
3.3. Antifungal Bioassay
3.3.1. Growth Recovery Test in Penicillium Strain Treated with High Temperatures: Agar Plate-Bioassay
3.3.2. Microtiter Plate (Microdilution) Liquid Bioassay
3.4. Statistical Analysis
4. Conclusions
| H2O2 | KA | ||||||
|---|---|---|---|---|---|---|---|
| Strains | Treatment | 28 °C | 35 °C | 45 °C | 28 °C | 35 °C | 45 °C |
| MICs, 48 h | |||||||
| Group A | Alone | 4.0 | ND a | ND a | 25.6 | ND a | ND a |
| Combined | 1.8 | ND a | ND a | 7.2 | ND a | ND a | |
| Group B | Alone | 8.0 | 2.3 | ND a | 25.6 | 25.6 | ND a |
| Combined | 5.3 | 1.3 | ND a | 17.6 | 11.7 | ND a | |
| Group C | Alone | 3.0 | ND a | ND a | 25.6 | ND a | ND a |
| Combined | 1.5 | ND a | ND a | 12.8 | ND a | ND a | |
| MFCs, 24 h | |||||||
| Group A | Alone | 7.0 | 2.0 | 0.6 | 25.6 | 25.6 | 25.6 |
| Combined | 4.0 | 1.0 | 0.3 | 11.2 | 12.8 | 11.2 | |
| Group B | Alone | 14.7 | 8.0 | 1.1 | 25.6 | 25.6 | 25.6 |
| Combined | 8.0 | 4.7 | 0.9 | 13.9 | 17.1 | 17.1 | |
| Group C | Alone | 3.0 | 1.0 | ND b | 25.6 | 25.6 | ND b |
| Combined | 2.5 | 1.0 | ND b | 19.2 | 25.6 | ND b | |
| MFCs, 48 h | |||||||
| Group A | Alone | 4.0 | 1.5 | 0.4 | 25.6 | 25.6 | 25.6 |
| Combined | 2.0 | 0.5 | 0.2 | 10.4 | 12.8 | 16.0 | |
| Group B | Alone | 8.0 | 4.0 | ND c | 25.6 | 25.6 | ND c |
| Combined | 4.7 | 2.7 | ND c | 13.9 | 19.2 | ND c | |
| Group C | Alone | 3.0 | 0.6 | ND d | 25.6 | 25.6 | ND d |
| Combined | 3.0 | 0.4 | ND d | 25.6 | 19.2 | ND d | |
Supplementary Materials
Acknowledgments
Author Contributions
Conflicts of Interest
References
- Liu, X.; Xia, W.; Jiang, Q.; Xu, Y.; Yu, P. Synthesis, characterization, and antimicrobial activity of kojic acid grafted chitosan oligosaccharide. J. Agric. Food Chem. 2014, 62, 297–303. [Google Scholar] [CrossRef] [PubMed]
- Rodrigues, A.P.D.; Farias, L.H.S.; Carvalho, A.S.C.; Santos, A.S.; do Nascimento, J.L.M.; Silva, E.O. A novel function for kojic acid, a secondary metabolite from Aspergillus fungi, as antileishmanial agent. PLoS One 2014, 9, e91259. [Google Scholar] [CrossRef] [PubMed]
- Bentley, R. From miso, sake and shoyu to cosmetics: A century of science for kojic acid. Nat. Prod. Rep. 2006, 23, 1046–1062. [Google Scholar] [CrossRef] [PubMed]
- Chang, T.S. An updated review of tyrosinase inhibitors. Int. J. Mol. Sci. 2009, 10, 2440–2475. [Google Scholar] [CrossRef] [PubMed]
- Lajis, A.F.; Hamid, M.; Ariff, A.B. Depigmenting effect of kojic acid esters in hyperpigmented B16F1 melanoma cells. J. Biomed. Biotechnol. 2012, 2012. [Google Scholar] [CrossRef] [PubMed]
- Leyden, J.J.; Shergill, B.; Micali, G.; Downie, J.; Wallo, W. Natural options for the management of hyperpigmentation. J. Eur. Acad. Dermatol. Venereol. 2011, 25, 1140–1145. [Google Scholar] [CrossRef] [PubMed]
- Bracarense, A.A.; Takahashi, J.A. Modulation of antimicrobial metabolites production by the fungus Aspergillus parasiticus. Braz. J. Microbiol. 2014, 45, 313–321. [Google Scholar] [CrossRef] [PubMed]
- Novotny, L.; Rauko, P.; Abdel-Hamid, M.; Vachalkova, A. Kojic acid—A new leading molecule for a preparation of compounds with an anti-neoplastic potential. Neoplasma 1999, 46, 89–92. [Google Scholar] [PubMed]
- Niwa, Y.; Akamatsu, H. Kojic acid scavenges free radicals while potentiating leukocyte functions including free radical generation. Inflammation 1991, 15, 303–315. [Google Scholar] [CrossRef] [PubMed]
- Rodrigues, A.P.; Carvalho, A.S.; Santos, A.S.; Alves, C.N.; do Nascimento, J.L.; Silva, E.O. Kojic acid, a secondary metabolite from Aspergillus sp., acts as an inducer of macrophage activation. Cell Biol. Int. 2011, 35, 335–343. [Google Scholar] [CrossRef] [PubMed]
- Chee, H.Y.; Lee, E.H. Fungistatic activity of kojic acid against human pathogenic fungi and inhibition of melanin production in Cryptococcus neoformans. Mycobiology 2003, 31, 248–250. [Google Scholar] [CrossRef]
- Ehrlich, K.C.; Cotty, P.J. An isolate of Aspergillus flavus used to reduce aflatoxin contamination in cottonseed has a defective polyketide synthase gene. Appl. Microbiol. Biotechnol. 2004, 65, 473–478. [Google Scholar] [CrossRef] [PubMed]
- Kim, J.H.; Mahoney, N.; Chan, K.L.; Campbell, B.C.; Haff, R.P.; Stanker, L.H. Use of benzo analogs to enhance antimycotic activity of kresoxim methyl for control of aflatoxigenic fungal pathogens. Front. Microbiol. 2014, 5, 87. [Google Scholar] [CrossRef] [PubMed]
- Frizzell, C.; Elliott, C.T.; Connolly, L. Effects of the mycotoxin patulin at the level of nuclear receptor transcriptional activity and steroidogenesis in vitro. Toxicol. Lett. 2014, 229, 366–373. [Google Scholar] [CrossRef] [PubMed]
- Vilanova, L.; Viñas, I.; Torres, R.; Usall, J.; Jauset, A.M.; Teixido, N. Infection capacities in the orange-pathogen relationship: Compatible (Penicillium digitatum) and incompatible (Penicillium expansum) interactions. Food Microbiol. 2012, 29, 56–66. [Google Scholar] [CrossRef] [PubMed]
- Dore, A.; Molinu, M.G.; Venditti, T.; D’Hallewin, G. Immersion of “Coscia” pear fruit in water at 55 degrees C for 60 sec controls Penicillium expansum decay and delays ripening during short storage. Commun. Agric. Appl. Biol. Sci. 2010, 75, 741–745. [Google Scholar] [PubMed]
- Cerioni, L.; Lazarte Mde, L.; Villegas, J.M.; Rodriguez-Montelongo, L.; Volentini, S.I. Inhibition of Penicillium expansum by an oxidative treatment. Food Microbiol. 2013, 33, 298–301. [Google Scholar] [CrossRef] [PubMed]
- Campbell, B.C.; Chan, K.L.; Kim, J.H. Chemosensitization as a means to augment commercial antifungal agents. Front. Microbiol. 2012, 3, 79. [Google Scholar] [CrossRef] [PubMed]
- Lavigne, J.P.; Brunel, J.M.; Chevalier, J.; Pages, J.M. Squalamine, an original chemosensitizer to combat antibiotic-resistant gram-negative bacteria. J. Antimicrob. Chemother. 2010, 65, 799–801. [Google Scholar] [CrossRef] [PubMed]
- Liu, S.; Hou, Y.; Chen, X.; Gao, Y.; Li, H.; Sun, S. Combination of fluconazole with non-antifungal agents: A promising approach to cope with resistant Candida albicans infections and insight into new antifungal agent discovery. Int. J. Antimicrob. Agents 2014, 43, 395–402. [Google Scholar] [CrossRef] [PubMed]
- Niimi, K.; Harding, D.R.; Parshot, R.; King, A.; Lun, D.J.; Decottignies, A.; Niimi, M.; Lin, S.; Cannon, R.D.; Goffeau, A.; et al. Chemosensitization of fluconazole resistance in Saccharomyces cerevisiae and pathogenic fungi by a D-octapeptide derivative. Antimicrob. Agents Chemother. 2004, 48, 1256–1271. [Google Scholar] [CrossRef]
- Kim, J.H.; Chan, K.L.; Mahoney, N.; Campbell, B.C. Antifungal activity of redox-active benzaldehydes that target cellular antioxidation. Ann. Clin. Microbiol. Antimicrob. 2011, 10, 23. [Google Scholar] [CrossRef] [PubMed]
- Musiol, R.; Mrozek-Wilczkiewicz, A.; Polanski, J. Synergy against fungal pathogens: Working together is better than working alone. Curr. Med. Chem. 2014, 21, 870–893. [Google Scholar] [CrossRef] [PubMed]
- Veri, A.; Cowen, L.E. Progress and prospects for targeting Hsp90 to treat fungal infections. Parasitology 2014, 141, 1127–1137. [Google Scholar] [CrossRef] [PubMed]
- Clinical and Laboratory Standards Institute (CLSI). Reference Method for Broth dilution Antifungal Susceptibility Testing of Filamentous Fungi: Approved Standard, 2nd ed.; CLSI document M38-A2; Clinical and Laboratory Standards Institute: Wayne, PA, USA, 2008; Volume 28. [Google Scholar]
- Li, H.X.; Xiao, C.L. Characterization of fludioxonil-resistant and pyrimethanil-resistant phenotypes of Penicillium expansum from apple. Phytopathology 2008, 98, 427–435. [Google Scholar] [CrossRef] [PubMed]
- Isenberg, H.D. Clinical Microbiology Procedures Handbook, 1 ed.; American Society for Microbiology: Washington, DC, USA, 1992. [Google Scholar]
- Macarisin, D.; Cohen, L.; Eick, A.; Rafael, G.; Belausov, E.; Wisniewski, M.; Droby, S. Penicillium digitatum suppresses production of hydrogen peroxide in host tissue during infection of citrus fruit. Phytopathology 2007, 97, 1491–1500. [Google Scholar] [CrossRef] [PubMed]
- Chatre, L.; Ricchetti, M. Are mitochondria the Achilles’ heel of the Kingdom Fungi? Curr. Opin. Microbiol. 2014, 20, 49–54. [Google Scholar] [CrossRef] [PubMed]
- Ma, Z.; Yoshimura, M.A.; Michailides, T.J. Identification and characterization of benzimidazole resistance in Monilinia fructicola from stone fruit orchards in California. Appl. Environ. Microbiol. 2003, 69, 7145–7152. [Google Scholar] [CrossRef] [PubMed]
- Jayasinghe, C.K.; Fernando, T.H. Growth at different temperatures and on fungicide amended media: Two characteristics to distinguish Colletotrichum species pathogenic to rubber. Mycopathologia 1998, 143, 93–95. [Google Scholar] [CrossRef] [PubMed]
- Kojima, K.; Takano, Y.; Yoshimi, A.; Tanaka, C.; Kikuchi, T.; Okuno, T. Fungicide activity through activation of a fungal signalling pathway. Mol. Microbiol. 2004, 53, 1785–1796. [Google Scholar] [CrossRef] [PubMed]
- Odds, F.C. Synergy, antagonism, and what the chequerboard puts between them. J. Antimicrob. Chemother. 2003, 52. [Google Scholar] [CrossRef] [PubMed]
- Kirkman, T.W. Statistics to Use. Available online: http://www.physics.csbsju.edu/stats/ (accessed on 16 September 2014).
- Dung, T.T.; Kim, S.C.; Yoo, B.C.; Sung, G.H.; Yang, W.S.; Kim, H.G.; Park, J.G.; Rhee, M.H.; Park, K.W.; Yoon, K.; et al. (5-Hydroxy-4-oxo-4H-pyran-2-yl)methyl 6-hydroxynaphthalene-2-carboxylate, a kojic acid derivative, inhibits inflammatory mediator production via the suppression of Syk/Src and NF-κB activation. Int. Immunopharmacol. 2014, 20, 37–45. [Google Scholar] [CrossRef]
- Sample Availability: Samples of the compounds, such as kojic acid and hydrogen peroxide, are available from the vendor described in this manuscript.
© 2014 by the authors. Licensee MDPI, Basel, Switzerland. This article is an open access article distributed under the terms and conditions of the Creative Commons Attribution license ( http://creativecommons.org/licenses/by/4.0/).
Share and Cite
Kim, J.H.; Chan, K.L. Augmenting the Antifungal Activity of an Oxidizing Agent with Kojic Acid: Control of Penicillium Strains Infecting Crops. Molecules 2014, 19, 18448-18464. https://doi.org/10.3390/molecules191118448
Kim JH, Chan KL. Augmenting the Antifungal Activity of an Oxidizing Agent with Kojic Acid: Control of Penicillium Strains Infecting Crops. Molecules. 2014; 19(11):18448-18464. https://doi.org/10.3390/molecules191118448
Chicago/Turabian StyleKim, Jong H., and Kathleen L. Chan. 2014. "Augmenting the Antifungal Activity of an Oxidizing Agent with Kojic Acid: Control of Penicillium Strains Infecting Crops" Molecules 19, no. 11: 18448-18464. https://doi.org/10.3390/molecules191118448







